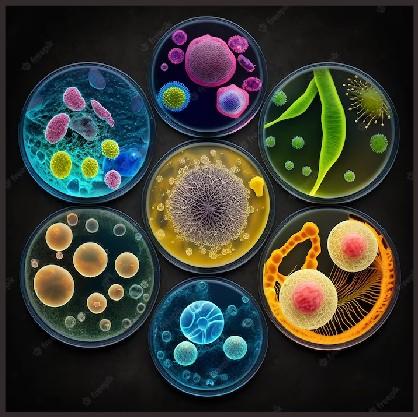

Enhancing Immunity: With Best Immune Booster Supplement

In today's world, maintaining a strong immune system is crucial for overall wellbeing and protection against illnesses.

- SDH Naturals has developed a powerful Ayurvedic supplement to enhance and support your immune system naturally.

-The immune system acts as the body's defense mechanism against harmful pathogens, viruses, and bacteria.

- A strong immune system helps prevent diseases and promotes faster recovery from illnesses.
-SDH Naturals' Ayurvedic immune booster supplement aims to strengthen your immune system naturally.

Key Features of SDH
Naturals' Immune Booster Supplement]
- M ade from all-natural Ayurvedic ingredients
- No artificial additives or preservatives
- Safe for long-term use

- Clinically tested and proven effectiveness
- M anufactured in a GM P -certified facility
Ayurvedic Ingredients

-Made from all-natural Ayurvedic ingredients
-No artificial additives or preservatives
- Safe for long-term use

-Clinically tested and proven effectiveness
-Manufactured in a GMP-certified facility
-Ashwagandha: Helps reduce stress and supports immune function.
-Tulsi (Holy Basil): Known for its antimicrobial and antioxidant properties.

-Amla (Indian Gooseberry): Rich in vitamin C and antioxidants, helps boost immunity.
-Giloy: Supports immune system function and helps fight infections.
-Turmeric: Exhibits anti-inflammatory and antioxidant effects.

Contact Us
- For more information or to purchase SDH Naturals' Ayurvedic immune booster supplement, visit our website at www.sdhnaturals.com or contact us at info@sdhnaturals.com.

